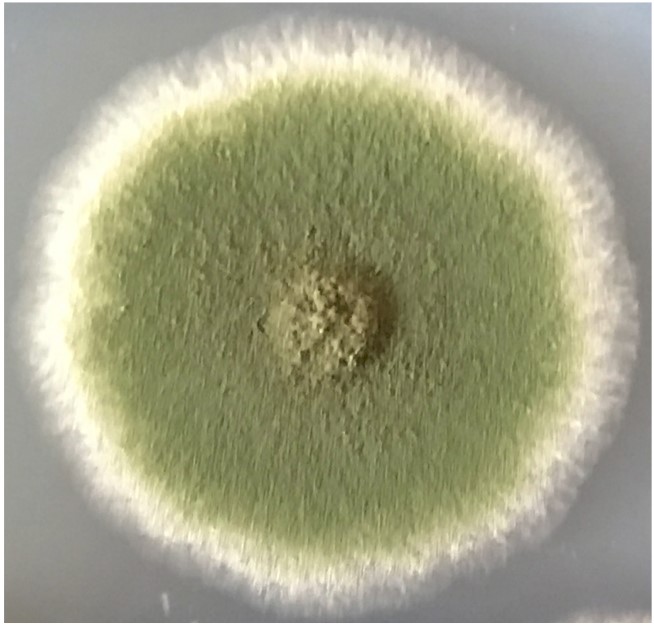

Research News
High-res imaging gives an unparalleled view of how fungi grow
Researchers centered at Japan's University of Tsukuba use super-resolution imaging to unravel events that drive growth of fungal cells
Tsukuba, Japan—Fungi are a diverse group of organisms that are ever-present in daily life; from the yeast used to ferment beer and the mushrooms at the supermarket to the pathogen responsible for athlete's foot. Many species of fungus grow by secreting enzymes - a process that can be co-opted as a biotechnology to make industrial and medical products.
In a study published in Science Advances, researchers centered at the University of Tsukuba report the use of high-resolution imaging to map out the complex sequence of events that drive this growth process in the fungus Aspergillus nidulans.
Most fungi grow through the extension of hyphae, which are fiber-like structures made of one or more cells encased within a single, long cell wall. The growing tip of a hypha is loaded with ChsB, a cell wall synthesis enzyme that helps to lengthen the cell wall. ChsB is carried through the hypha by small cellular sacs called vesicles. In order for hyphae to grow, the transport and release of ChsB by these vesicles needs to be precisely timed - and exactly how this timing is achieved is unclear.
"Two different types of vesicles are used to transport cargo to and from the hyphal tip," corresponding author Norio Takeshita explains. "Prior work in the field suggested that secretory vesicles (SVs) were involved in transporting ChsB. This was only a hypothesis, though, and many details were missing because the images used to visualize transport were collected at limited time points and had a lot of background noise."
To address these shortcomings, the researchers used a technique called high-speed pulse-chase imaging, which allowed them to follow ChsB by fusing it to a marker emitting red fluorescent light. After bleaching away background red light using a laser beam, a separate beam was aimed at a single spot in the hypha, causing ChsB to fluoresce. The team was then able to trace the movement of the fluorescent ChsB as vesicles carried it around the hypha.
The technique resulted in minimal background and allowed images to be taken, on average, every 50 milliseconds - a level of precision not previously seen in hyphae. Correspondingly, the study yielded many new insights into the timing of vesicle movement during fungal growth.
"Our main finding how motor proteins ensure the supply of vesicles to the hyphal tip." Takeshita concludes. "We also show for the first time that different types of vesicles move along the hypha at different velocities. The technique allowed us to uncover several mechanistic details we think will greatly aid efforts to use fungal species for agricultural and other forms of biotechnology."
Original Paper
The article, "Superresolution and pulse-chase imaging reveal the role of vesicle transport in polar growth of fungal cells," was published in Science Advances 24 Jan 2018: Vol. 4, no. 1, e1701798 DOI: 10.1126/sciadv.1701798